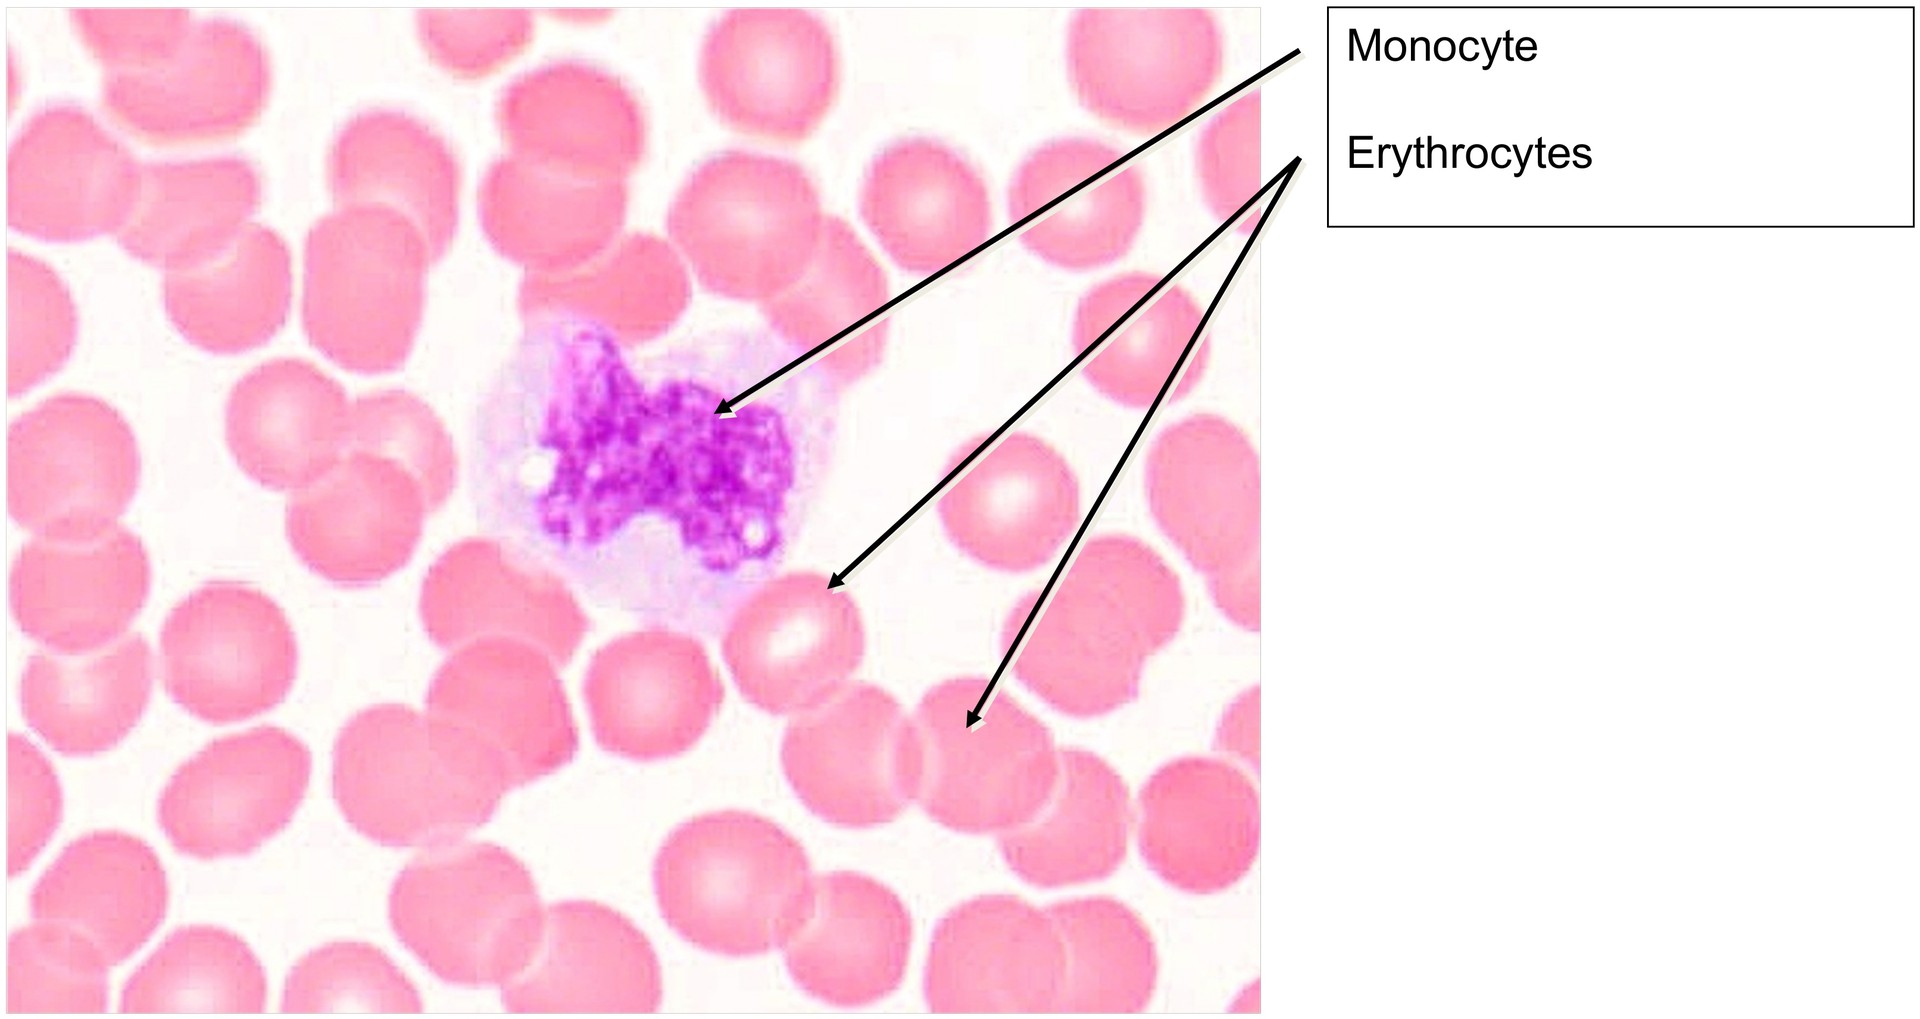
Blood smear
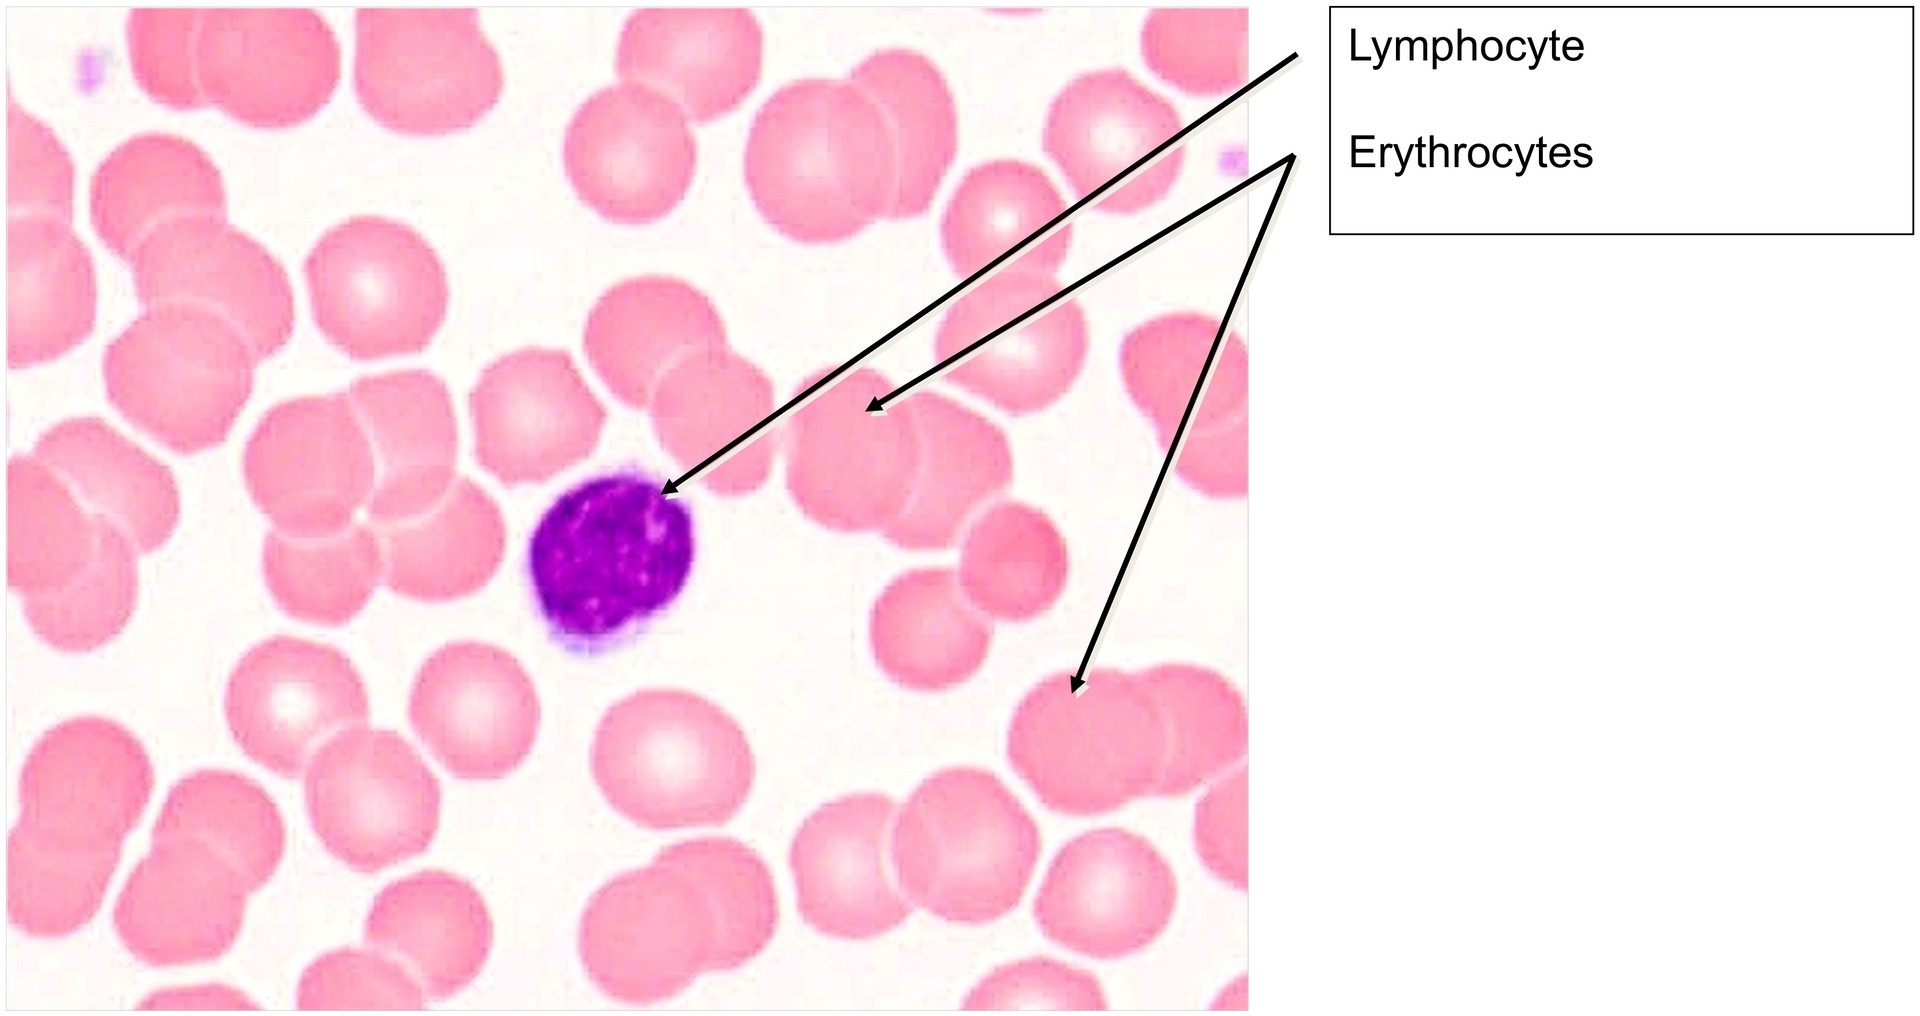
Blood smear
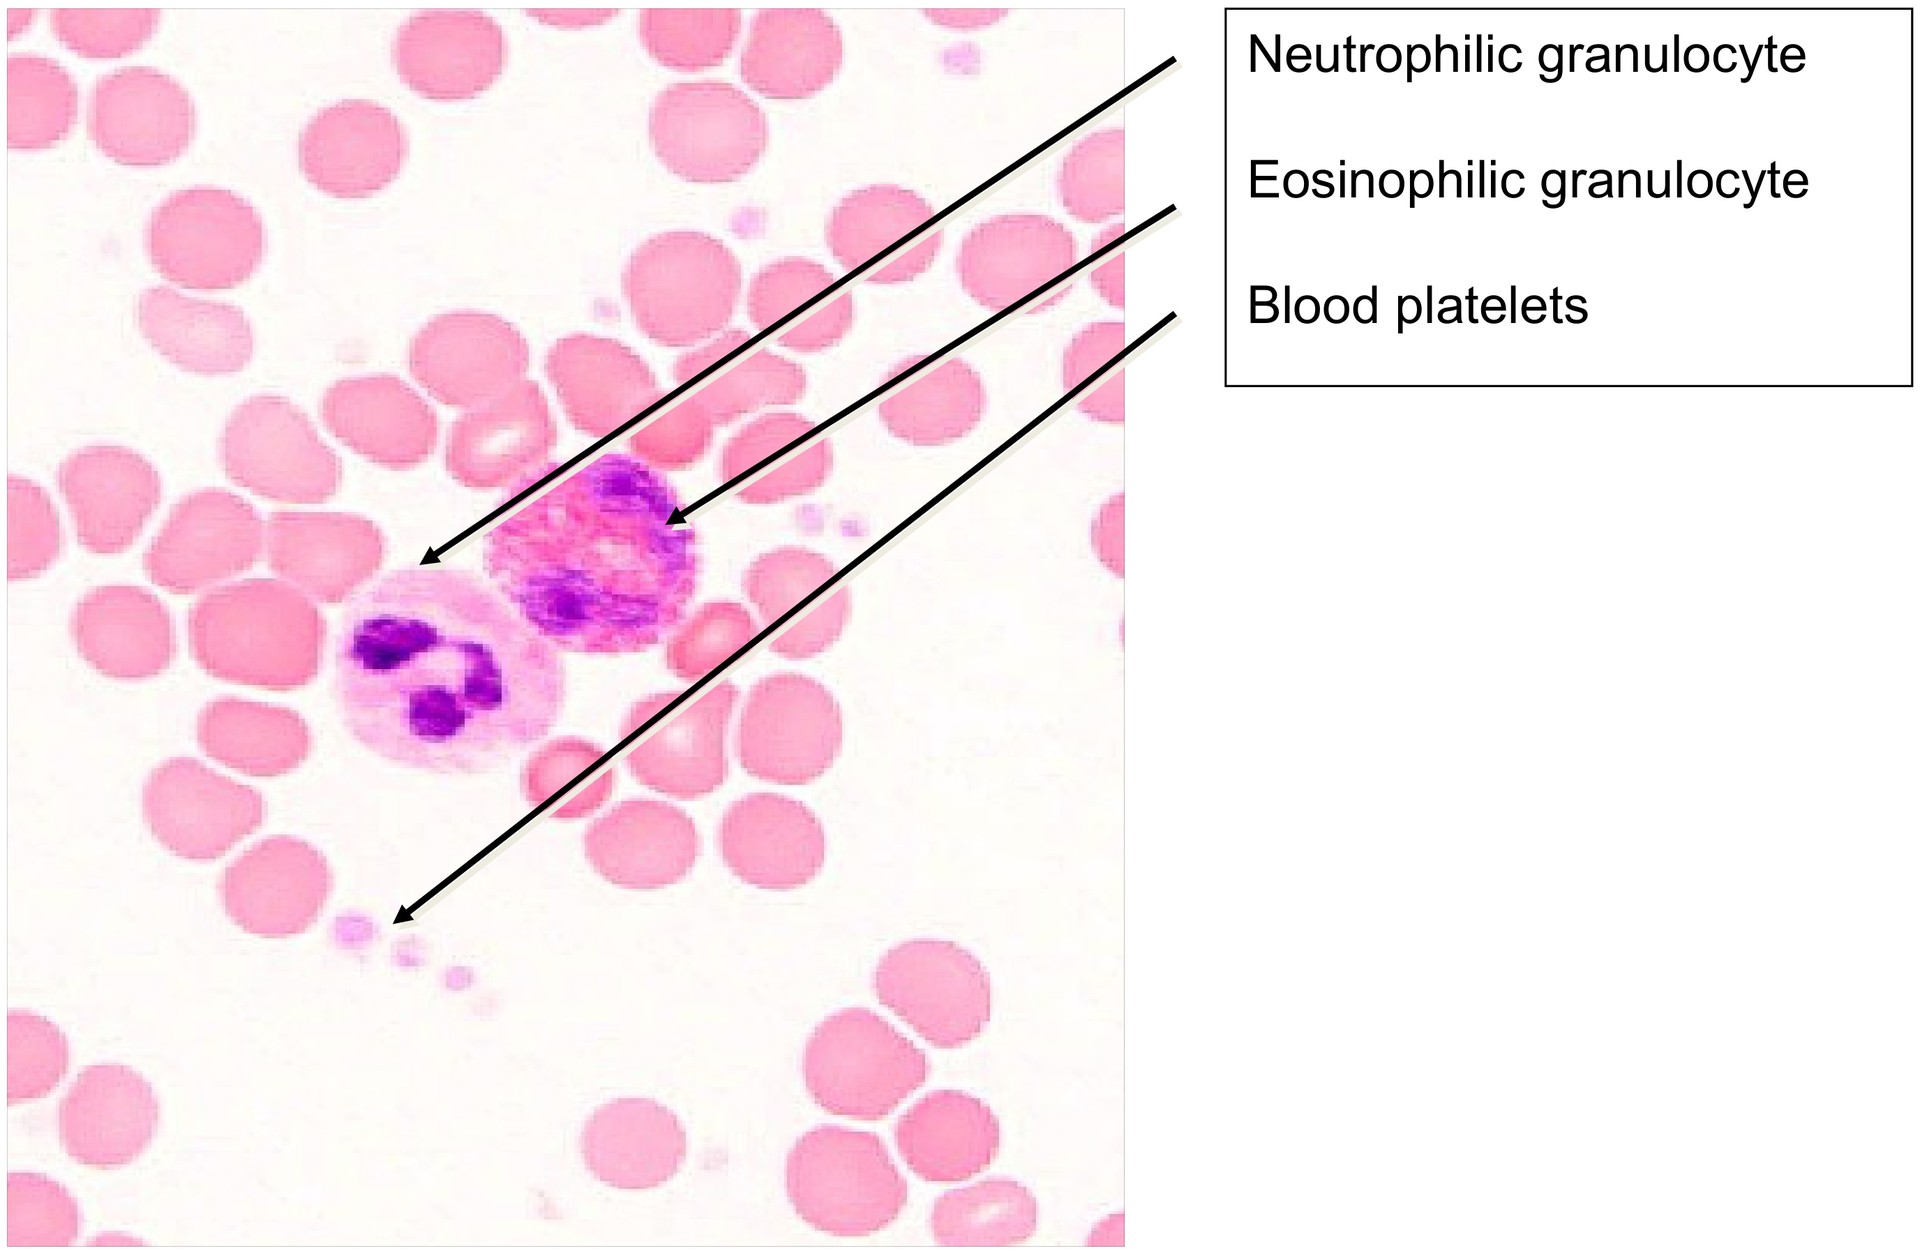
Blood smear
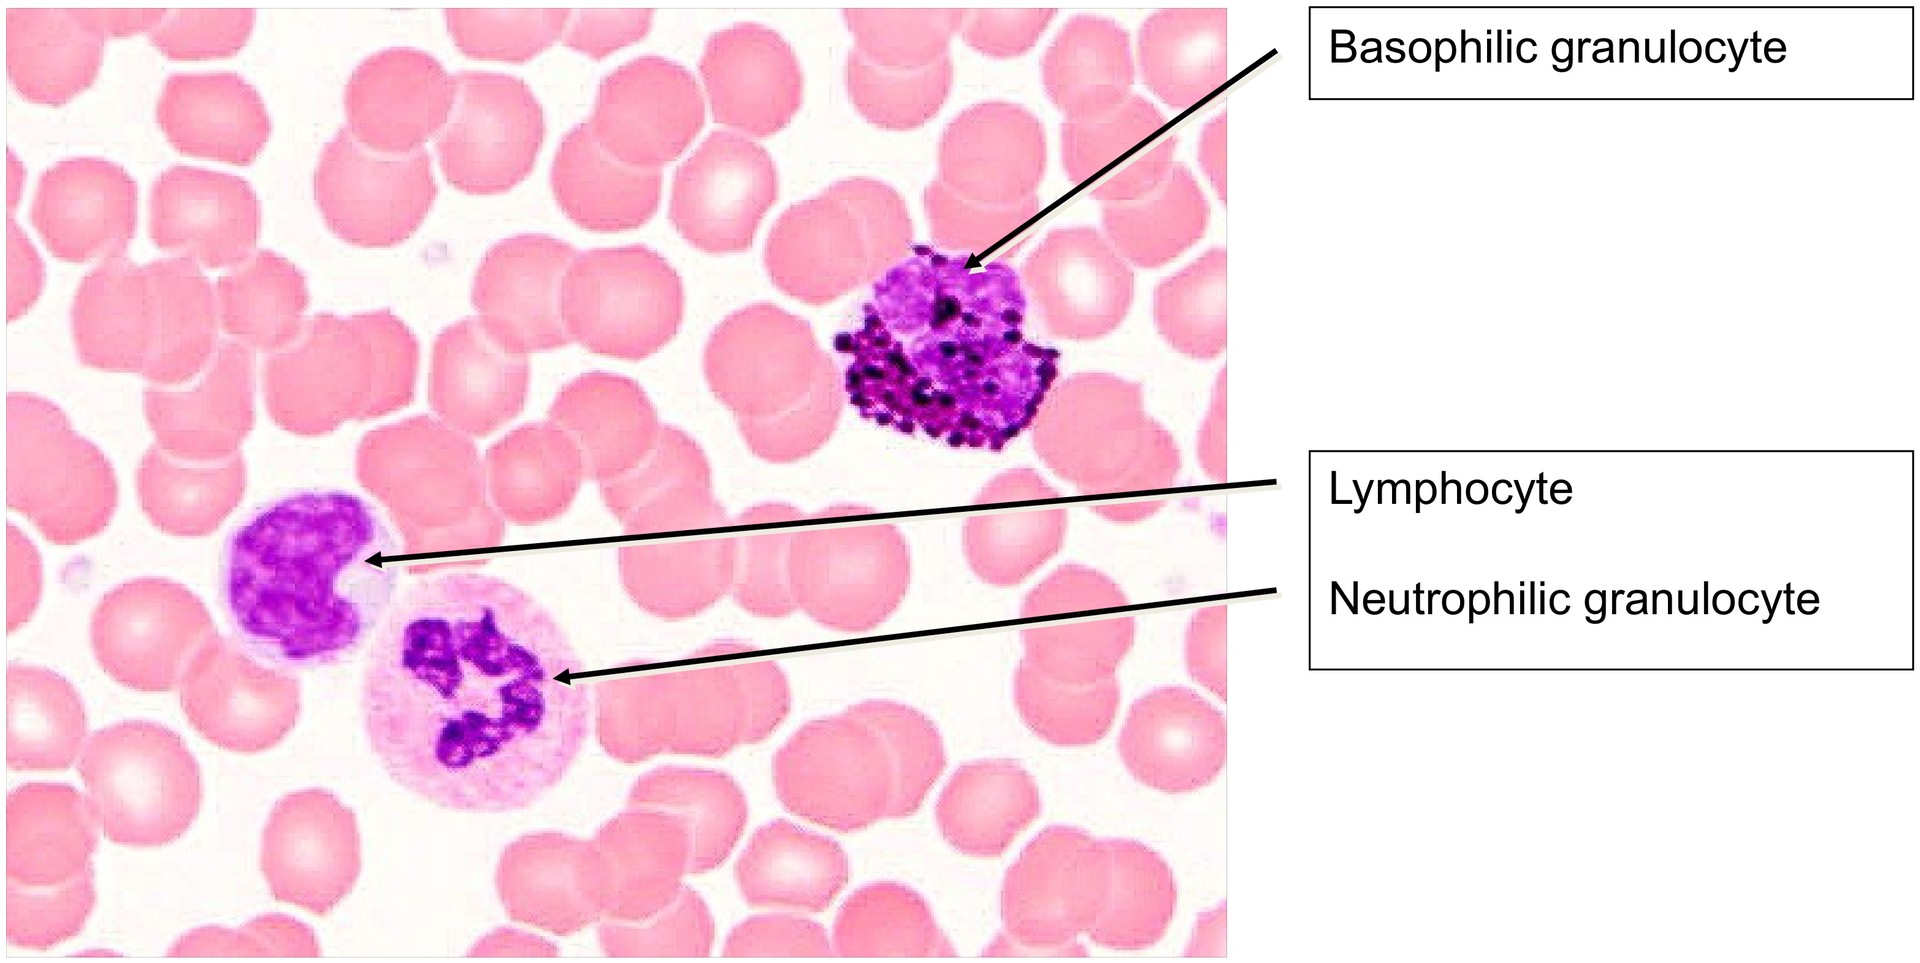
Blood smear
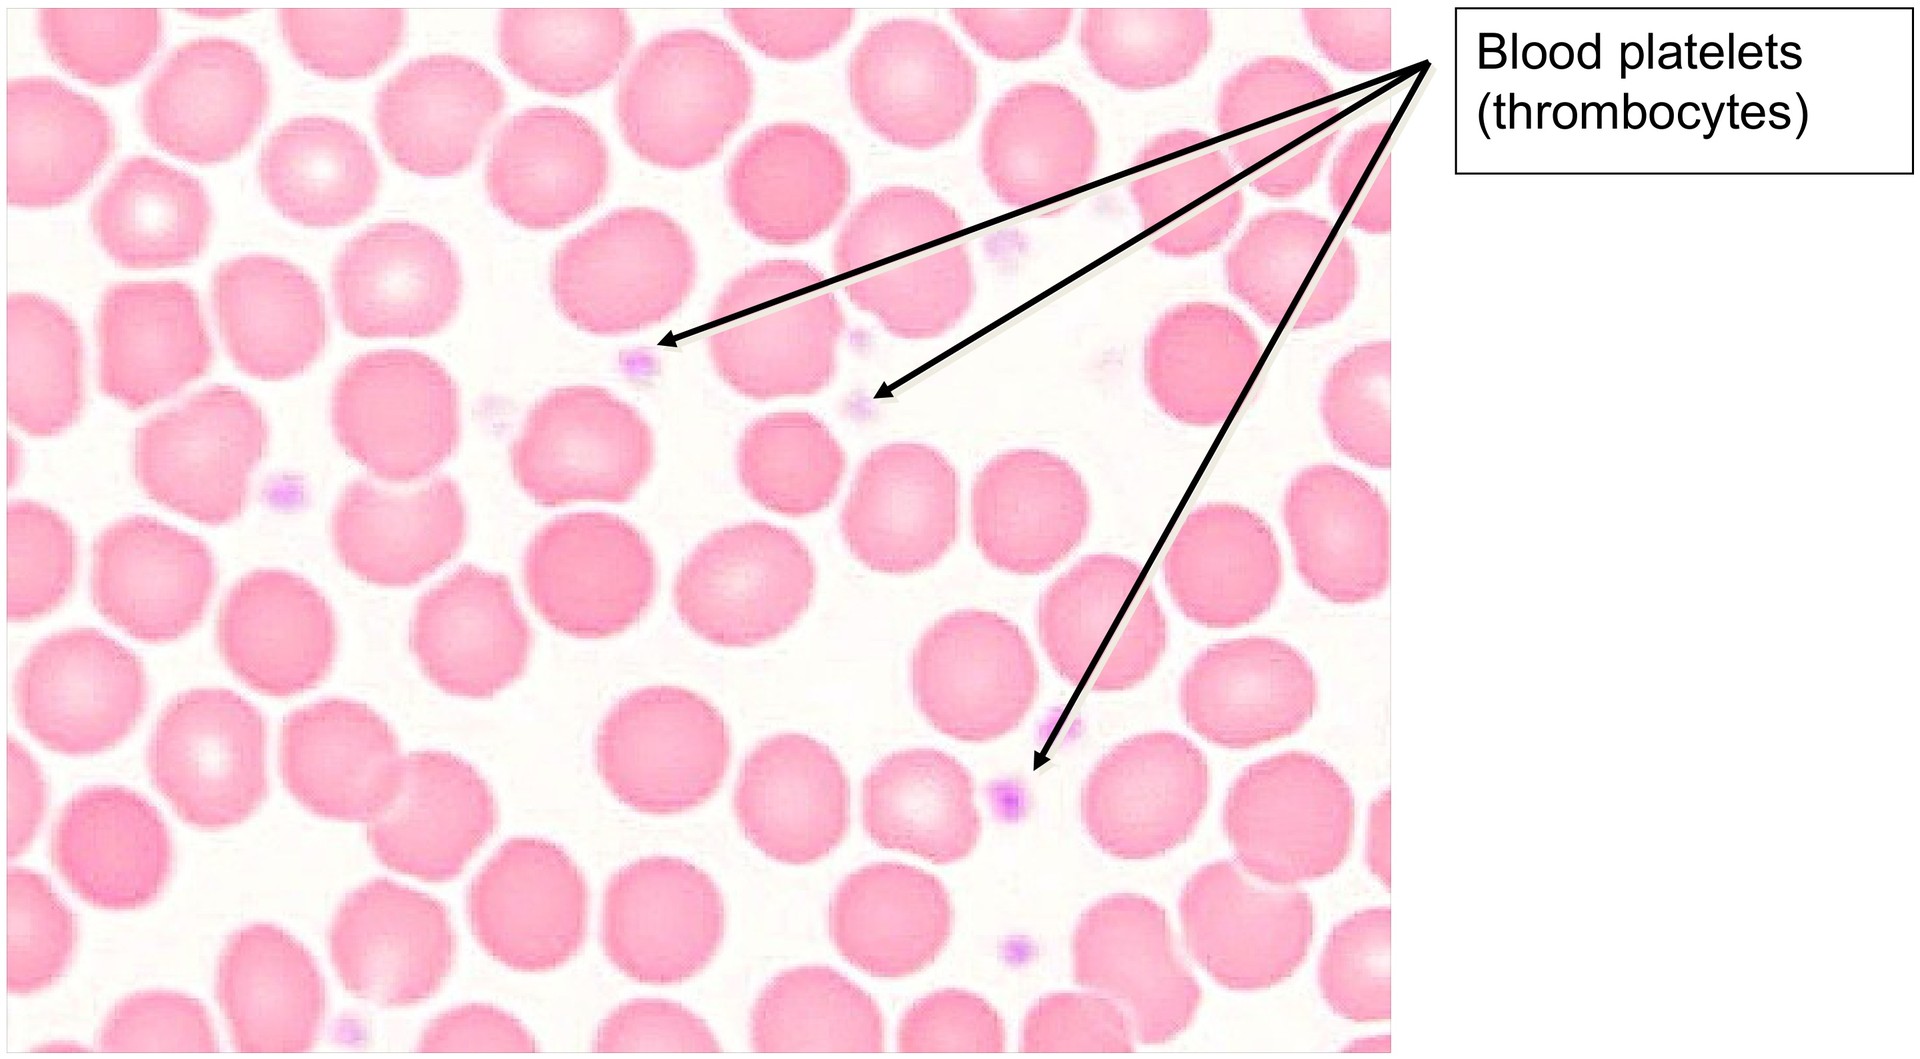
Blood smear

CARDIOVASCULAR ORGANS (ANATOMICAL MICROSCOPY)
14.4
Blood smear
Preparation:
Preparation Details:
Organ: Peripheral Blood
Origin: Human
Staining: May–Grünwald–Giemsa (MGG)
Method and Specimen Description:
A drop of fresh human blood was smeared onto a glass slide and air-dried. This technique causes slight flattening of the blood cells but preserves their structure. The May–Grünwald–Giemsa stain enables excellent differentiation between erythrocytes, leukocytes, and platelets, as well as identification of individual leukocyte subtypes. The cell distribution corresponds to normal peripheral blood composition.
Objective of the Examination:
To acquire knowledge of the shape, size, and distribution pattern of the formed elements of blood. Before studying the preparation, the reference values for their relative numbers per mm³ should be known (see chart).
Special Features of the Preparation:
In accordance with the normal composition of blood, leukocytes are relatively rare; to observe individual types, the smear must be examined carefully. Because perfect distribution of the blood drop across the slide is technically difficult, focus on regions with a loose but even spread of cells.
At medium magnification, the stained nuclei of leukocytes are clearly visible. The diameter of erythrocytes (≈7.5 µm) serves as a reference for cell size comparison. When flattened and illuminated, erythrocytes show a pale central zone, corresponding to their biconcave shape, where the cell is thinnest.
The major leukocyte types can be identified based on nuclear shape and cytoplasmic granulation, as summarized in the chart.
Neutrophils are the most common type of white blood cell found in a blood smear. They make up 60-70% of the total amount of white blood cells. They are motile, and phagocytic and will destroy damaged tissue and bacteria.
Eosinophils make up 1-6% of the total white blood cells. They phagocytose antigen-antibody complexes. They also produce histaminase, and aryl sulphatase B, two enzymes that inactivate inflammatory agents released by mast cells.
Basophils are the rarest type of white blood cell, making up only 1% of the white blood cells found in a blood smear. These cells are involved in immune responses to parasites. They have IgE receptors and the granules are released when the cells bind IgE.
Lymphocytes are the second most common white blood cell (20-50%) and are easy to find in blood smears. The two subtypes (B and T) cannot be distinguished based on their morphology. The B-cells develop into plasma cells which produce antibodies, the T-cells attack viruses, cancer cells, and transplants.
Monocytes account for 2 – 10 % of the leukocytes. Monocytes in the circulation are precursors of tissue macrophages that are actively phagocytic.
Both monocytes and lymphocytes are sometimes referred to as agranulocytes.
Platelets (Thrombocytes): Small, irregularly shaped cell fragments (1.5–3.5 µm) often found in clusters of 2–5. Though inconspicuous in size, they are essential for hemostasis and clot formation.
Tasks:
- Compare the relative sizes of erythrocytes, leukocytes, and platelets.
- Identify the following formed blood elements:
- Erythrocytes
- Lymphocytes
- Monocytes
- Neutrophilic Granulocytes
- Eosinophilic Granulocytes
- Basophilic Granulocytes
- Recognize the difference in frequency between erythrocytes (≈4.6–5.2 million/mm³) and leukocytes (≈4,000–9,000/mm³).
- Locate and identify platelets (thrombocytes) and note their tendency to cluster.

License
University of Basel
Downloads